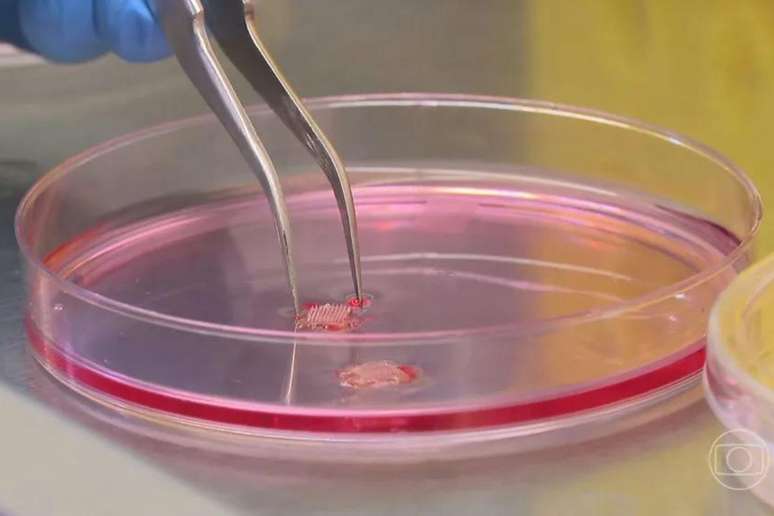

Universidades brasileiras desenvolvem adesivo que substitui agulha na aplicação de vacinas
O produto já foi testado nas peles humana e animal de um banco de pele internacional e agora serão realizadas experimentações em animais vivos
Pesquisadores da UFMG, em parceria com uma rede de cientistas de diferentes universidades brasileiras, estão desenvolvendo um adesivo que substitui seringas e agulhas na aplicação de vacinas, com cerca de 5mm.
Testes
Em um primeiro momento, o adesivo foi testado em peles humana e animal de um banco de pele internacional. Já que não foram observadas irritação, alergia ou inflamação, os testes passaram para o próximo passo.
Agora, serão realizadas experimentações em animais vivos com a intenção de verificar se o produto é tóxico. Por isso, nessa etapa, não serão utilizados imunizante no adesivo.
"O uso em camundongos, que é o modelo animal, em que você vai ver se tem algum problema sistêmico, se isso pode causar alguma alteração sistêmica, ou seja, se vai causar toxicidade nos rins, se vai causar toxicidade no fígado, se o animal vai sentir desconforto por ter essa aplicação", contou a pesquisadora da UFMG Lídia Andrade.
Última etapa
A última etapa de teste deve ocorrer até 2025. Nesta, o adesivo será testado com imunizantes: Em um primeiro momento com animais e, depois, em humanos. O adesivo possui micro agulhas de menos de 1 mm.
O objetivo do produto é não causar incômodo ou dor ao entrar em contato com a pele. Ele poderá ser aplicado em qualquer parte do corpo, mas, para que possa ter efeito, só poderá ser retirado após uma hora.
De acordo com Agência Nacional de Vigilância Sanitária (Anvisa), não há no Brasil vacinas registradas na forma de adesivo para aplicação em humanos e ainda não há previsão de quando os adesivos imunizantes vão estar disponíveis no mercado.
"Acredito que, com essa tecnologia, a gente vai ter mais adeptos a receber os medicamentos. A cobertura vacinal aumenta, fora as demais aplicações dessa tecnologia", explicou o pesquisador da UFMG
Guilherme Mattos Jardim Costa.
*Texto sob supervisão de Barbara Câmara.

-(1)-1ibea6sih6x4n.png)

Comentários
Os comentários são de responsabilidade exclusiva de seus autores e não representam a opinião deste site. Se achar algo que viole os termos de uso, denuncie.